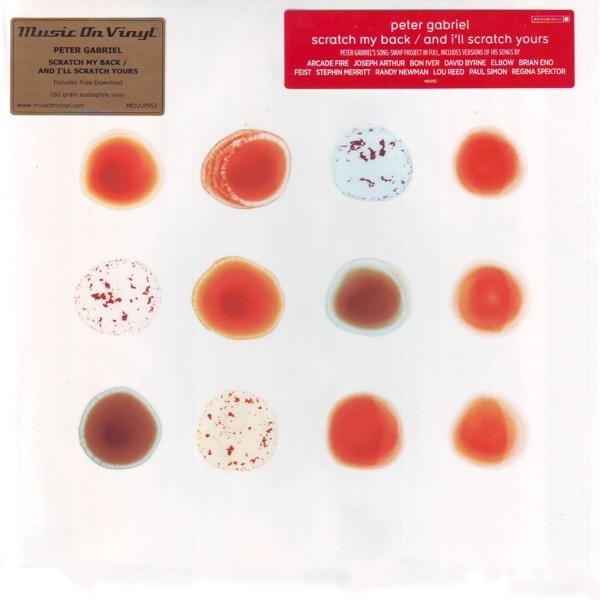

|
WITAMY SERDECZNIE NA AUKCJI SKLEPU INTERNETOWEGO najlepszamuzykapl
Wszystkie wystawiane przez nas płyty CD, DVD i LP są oryginalne i nowe. Dajemy gwarancję na wszystkie wystawiane przez nas artykuły. Każdy nabywca otrzymuje paragon fiskalny. Wystawiamy również na życzenie faktury VAT.
Przedmiotem tej aukcji jest NOWA (ORYGINALNIE ZAFOLIOWANA) płyta analogowa "2LP":
PETER GABRIEL SCRATCH MY BACK / AND I'LL SCRATCH YOURS
180 GRAM PRESSING
2LP + MP3 DOWNLOAD
Lista utworów:
A01. HEROES (DAVID BOWIE)
A02. THE BOY IN THE BUBBLE (PAUL SIMON)
A03. MIRRORBALL (ELBOW)
A04. FLUME (BON IVER)
A05. LISTENING WIND (TALKING HEADS)
A06. THE POWER OF THE HEART (LOU REED)
B07. MY BODY IS A CAGE (ARCADE FIRE)
B08. THE BOOK OF LOVE (THE MAGNETIC FIELDS)
B09. I THINK IT'S GOING TO RAIN TODAY (RANDY NEWMAN)
B10. APRES MOI (REGINA SPEKTOR)
B11. PHILADELPHIA (NEIL YOUNG)
B12. STREET SPIRIT (RADIOHEAD)
C13. DAVID BYRNE - I DON'T REMEMBER
C14. BON IVER - COME TALK TO ME
C15. REGINA SPEKTOR - BLOOD OF EDEN
C16. STEPHIN MERRITT - NOT ONE OF US
C17. JOSEPH ARTHUR - SHOCK THE MONKEY
C18. RANDY NEWMAN - BIG TIME
D19. ARCADE FIRE - GAMES WITHOUT FRONTIERS
D20. ELBOW - MERCY STREET
D21. BRIAN ENO - MOTHER OF VIOLENCE
D22. FEIST - TIMBER TIMBRE - DON'T GIVE UP
D23. LOU REED - SOLSBURY HILL
D24. PAUL SIMON - BIKO
REAL WORLD/MUSIC ON VINYL © 2010/2013 (2013)
Nr.Katalogowy: MOVLP952
Kod kreskowy: 88108002339
TYP OKŁADKI: GATEFOLD
ILOŚĆ NOŚNIKÓW: 2xLP
PŁYTA NOWA ORYGINALNIE ZAFOLIOWANA

|
ZOBACZ nasze pozostałe aukcje - świetne tytuły od SUPER SPRZEDAWCY! Nie przegap :) 
|
|
|
|
|
|
|
|
|
|
|
|
|
|